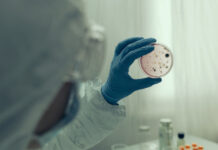
Эксперт Гемотест Демьяновская рассматривает контроль холеры Vibrio cholerae ekspert gemotest demyanovskaya rassmatrivaet kontrol holery -urbandigest-ru-174583221700-0

В России отмечается возрастание числа случаев завоза такой инфекции, как брюшной тиф. Как рассказала руководитель Роспотребнадзора Анна Попова, наибольший риск заражения сохраняется для путешественников в азиатские и африканские регионы, где уровень заболеваемости этим недугом гораздо выше. Тем не менее, развитые методы профилактики позволяют эффективно предупреждать болезнь. О важных аспектах диагностики, лечения и предотвращения брюшного тифа рассказывает врач-терапевт, клинический фармаколог Андрей Кондрахин.
Что представляет собой брюшной тиф
Брюшной тиф — это серьезное инфекционное заболевание, вызываемое патогенными бактериями рода сальмонелла. В неблагоприятных санитарных условиях бактерия легко проникает в организм через воду и пищу, а также при контакте с зараженными предметами, грызунами и их выделениями. После попадания внутрь бактерии размножаются в кишечнике и затем, распространяясь по лимфатическим и кровеносным путям, провоцируют тяжелое системное заражение.
Основные риски пребывания в эндемичных регионах связаны с низким уровнем санитарии. При этом заразиться можно довольно просто — достаточно выпить некипяченой воды или съесть загрязненные продукты. Андрей Кондрахин подчеркивает, что на внутренние органы приходится основная нагрузка: сильнее всего страдает желудочно-кишечный тракт, однако болезнь может затрагивать и другие системы организма.
Основные проявления и симптомы заболевания
Брюшной тиф отличается выраженными клиническими проявлениями. Среди наиболее типичных симптомов — резкое недомогание, отсутствие аппетита и отказ от пищи и питья из-за общего токсического воздействия бактерий. Болезнь сопровождается характерным состоянием «жесткого» живота: полностью нарушается работа пищеварительного тракта, иногда возможна болезненность при пальпации. Помимо этого, наблюдаются продолжительная лихорадка, слабость, головная боль и общее ощущение интоксикации организма.
Андрей Кондрахин отмечает, что игнорировать симптомы нельзя — брюшной тиф опасен своими осложнениями. При отсутствии своевременной медицинской помощи заболевание может привести к тяжелым последствиям, вплоть до летального исхода. К счастью, в настоящее время современные методы лечения позволяют значительно снизить риски для пациентов даже при серьёзном течении болезни.
Современные подходы к лечению и профилактике
Диагностика и лечение брюшного тифа требуют комплексного профессионального подхода. Врач-терапевт подчеркивает, что одним из важнейших средств борьбы с болезнью является антибиотикотерапия. Под грамотным медицинским наблюдением и с использованием препаратов можно добиться быстрого выздоровления, а при соблюдении всех рекомендаций минимизируется угроза осложнений.
Особое внимание уделяется профилактике: существует эффективная вакцина против брюшного тифа, которую особенно рекомендуется сделать тем, кто планирует поездку в регионы с повышенным риском заражения. Вакцинация существенно снижает вероятность развития болезни и позволяет путешественникам чувствовать себя увереннее и спокойнее, а также способствует формированию коллективного иммунитета.
Кроме вакцинации, Кондрахин советует соблюдать правила элементарной гигиены: пить только бутилированную воду, тщательно мыть руки и фрукты, избегать сомнительных мест общественного питания. Эти простые меры остаются действенным способом защитить себя и своих близких от серьезных инфекций.
Гранулоцитарный анаплазмоз: что важно знать
Современная медицинская статистика сообщает о возросшем числе случаев выявления гранулоцитарного анаплазмоза — заболевания, которое передается через укусы клещей. Как показали недавние исследования, у порядка двух процентов из пяти тысяч жителей Московской области был зафиксирован возбудитель этого заболевания, после того как они обратились к медикам с укусом клеща.
Анаплазмоз проявляется схожими с гриппом симптомами: отмечается лихорадка, озноб, мышечные и суставные боли, учащенное сердцебиение. Без соответствующего лечения заболевание может привести к осложнениям, но при своевременном обращении к врачу прогноз благоприятный. Важная рекомендация — при обнаружении укуса клеща не заниматься самолечением, а немедленно обратиться к специалистам, где будут проведены необходимые анализы и назначена терапия.
Знание основных принципов профилактики и своевременное реагирование на первые признаки инфекционных заболеваний позволяют эффективно справляться даже с серьезными вызовами современного мира. Опыт ведущих специалистов, таких как Анна Попова и Андрей Кондрахин, подтверждает: правильное информирование, забота о здоровье и ответственное отношение к прививкам способны надежно обезопасить людей от тяжелых инфекций.
Источник: vm.ru